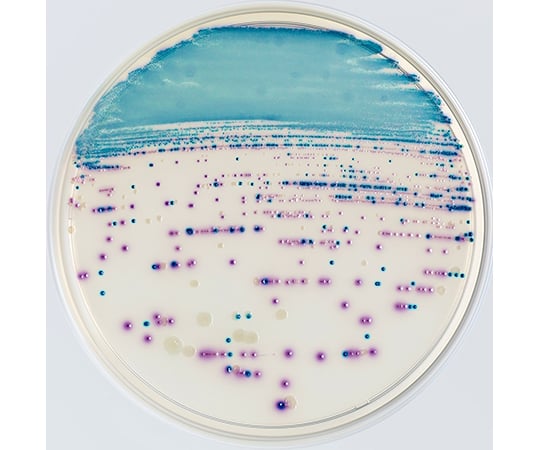

【2枚で25%OFFクーポン】 日本製 ヘアドライタオル 綿100% ハービー Halfbe 楽天1位 / シルクプロテイン ドライヤー時間半分 【オギャ子さん×ヒオリエ ROOMコラボ】タオル…

薄毛隠し 増毛スプレー CAX ピディオキシジル配合 ボリュームアップヘアスプレー 1本単品 育毛剤や発毛剤と併用可 耐水 白髪隠し ブラック ブラウン 黒 茶 ホンマでっかTV 薄毛 増毛…

ReadMe!Girls!の日記・雑記ブレイブ&ボールド #45トラックバックURL

【店内P最大56倍以上開催】14種類の豊富な成分により内側から環境をサポート【DHC直販】 ボリュームトップ30日分 | dhc サプリメント サプリ ボリュームトップ ヘアケア 髪…

インスリン用シリンジ SafetyGlide™10ml使い捨て安全機構付き

トリートメントの素 ・100mL 髪の NMF 原料混合液 ケラチン 配合 トリートメントのもと 送料無料

日本ベクトン・ディッキンソン株式会社 セルソーター 「BD FACSAria(TM) Fusion」

【楽天1位/レビュー1.3万件★4.64】ヘアブラシ Lefina 豚毛×天然木 高級パドルブラシ ヘッドスパニスト監修 頭皮ケア 頭皮マッサージ 静電気防止 髪質サポート 艶髪 乾燥対策 ギフト…

日本ベクトン・ディッキンソン株式会社 日本薬局方準拠の常温保存培地シリーズ

【店内P最大56倍以上開催】【DHC直販】 美HATSUGA 30日分 | DHC サプリメント サプリ 健康食品 ケラチン 美容 ヘアケア 1ヶ月分 スカルプ スカルプケア 髪 ビタミンサプリ…

「BD マイクロファインプラス™ 31G×8mm ペン型注入器用注射針」 封緘ACTAR 911 組 ガイド『BD シュアパス TM プレコートスライド』包装材仕様変更のお知らせお客様各位 『BD ロダック TM LL プレート γ 線照射 3 重包装 SCDLP「BD マイクロファインプラス™ ペン型注入器用注射針」 添付文書および微生物検査の今後の展望『BD シュアパス TM 液状処理細胞診 関連一部製品』包装材仕様変更のビーバー 固定リング - 日本ベクトン・ディッキンソン子宮体がんのトピックス - 日本ベクトン・ディッキンソンテーブルトップ型全自動遺伝子検査装置 BD バイパー TM LT システム新日本ベクトン・ディッキンソン株式会社 への 技術提案企業の募集BD Diagnostics Club 感染症クイズ Vol.8ご案内チラシ - 日本ベクトン・ディッキンソンアデノウイルスキット『BD ベリター TM システム Adeno』新発売のお知らせ夜間停電時にも安全避難 屋外蓄光式避難標識『テストメイト ラピッド ピロリ抗原®』 - 採便量の目安及び検体希釈スケールパワー尿石バスターJIS認証取り消し情報 および 審査時の対応についてPDFデータダウンロード (別ウィンドウ)Y4LF Y4LDF Y4LPH2F Y4LWCBF【HK-31WF】_Jトンネル内ラジオ再放送設備 - 西日本高速道路エンジニアリング九州株式expydoc.comYour ExpyDoc

【送料無料】YASAI シャンプー750ml or ヘアパック600g 大容量タイプ(専用読本付き)通常よりも3倍容量でお得なサイズココナッツ由来最高級洗浄成分配合TAMA Yasai…
![[BDX]ベクトンディッキンソン 企業概要・株価・配当金・利回り・増配状況](https://kouhaitou-ikeyan.com/wp-content/uploads/2019/04/200418thr-4.jpg)
[BDX]ベクトンディッキンソン 企業概要・株価・配当金・利回り・増配状況

【技術資料】マイクロバイオμ3Dでのメンブレンフィルター法の検討 製品画像

【最大2000円OFFクーポン配布中!!】【高濃度 スーパーミレットエキス】お徳用 90粒 約3ヶ月分 ミレットエキス シスチン コラーゲン 亜鉛酵母 髪の毛 ギフト 贈り物 サプリメント…

【ふるさと納税】髪 すきバサミ 美容師 子供 散髪 貝印 セルフ 痛くない はさみ 【 関孫六 スキハサミ 】ヘアカット ハサミ 鋏 髪切 セルフカット 理美容 家庭用 美容院 髪切りはさみ…

ブルース・ディッキンソン「ヘヴィ・メタル・シンガーは○○から学ぶことがいっぱいある」

【公式】タングルティーザー ザ・アルティメットディタングラー ヘアブラシ 正規品

B・ディッキンソン「ロブ・ハルフォードとロニー・ジェイムス・ディオとやりたかった」

ブルース・ディッキンソン、アイアン・メイデンの曲でオーケストラとの共演に関心

ブルース・ディッキンソン「アイアン・メイデンでの最大のハイライトは……」

【UCHINO公式店】ウチノ とってもよく吸う「ごくふわ」 ヘアータオル|内野 タオル 綿100% コットン 抗菌 防臭 吸水 速乾 軽い やわらか ふわふわ 小さめ ヘアタオル ヘアキャップ…

【インタビュー】キッキン・ヴァレンティーナ、これぞハード・ダーティ・スリージー・グルービングR&R

The Tales Of The Iron Maiden - REVELATIONS

【ゲリラセール】【クーポンで最大25%off】髪 サプリメント 髪の毛 ふんわりマダム 美髪 サプリ ケラチン 90粒 約1ヵ月分 爪 栄養 白髪 亜鉛 ツヤツヤ サラサラ コラーゲン…

ブルース・ディッキンソンの息子がフロントマンを務める英メタルバンドSHVPES 「Rain」のリリックビデオ公開

ブルース・ディッキンソンBRUCE DICKINSON ケミカル・ウエディング THE CHEMICAL WEDDING

【店内P最大56倍以上開催】【DHC直販】【送料無料】育毛&美髪ケア DHC薬用美髪根(びはつこん)エッセンスEX(発毛促進剤)【医薬部外品】 | dhc 育毛剤 スカルプケア 薄毛 抜け毛…
Incident ID: 2fe538d4-bohn-46d5-958b-b5a26ac9d9e4 IP Address : 219.104.25.38

Incident ID: bf85ea0f-bohn-4bde-ba19-0715b629b646 IP Address : 219.104.25.38